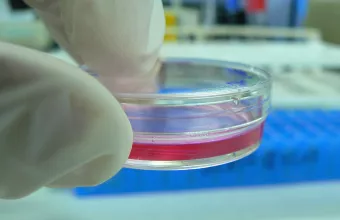
Διάγνωση

Bloomberg: Η Κίνα εξετάζει την αναστολή του δασμού 125% σε ορισμένες εισαγωγές από τις ΗΠΑ
ΟικονομίαΟι αρχές της Κίνας εξετάζουν το ενδεχόμενο κατάργησης των πρόσθετων δασμών για ιατρικό εξοπλισμό και ορισμένα βιομηχανικά χημικά, όπως το αιθάνιο
0 11